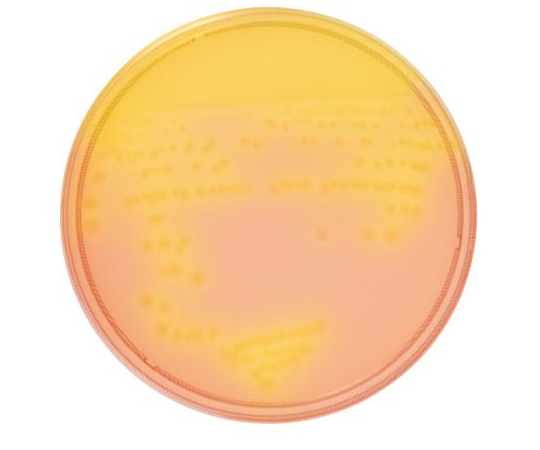
63-6527-31 BD BBL（TM） CCFA培地 10枚 251983 【AXEL】 アズワン

上品なスタイル 受け継がれる意志 2box 63-6527-31 BD BBL(TM) CCFA培地 10枚 251983 【AXEL】 アズワン ワンピース カードゲーム
(3037件)
Pontaパス特典
サンキュー配送
8932円(税込)
90ポイント(1%)
Pontaパス会員ならさらに+1%ポイント還元!
送料
(
)
3022
配送情報
お届け予定日:2026.04.24 22:10までにお届け
※一部地域・離島につきましては、表示のお届け予定日期間内にお届けできない場合があります。
ロットナンバー
58817251983
お買い物の前にチェック!

Pontaパス会員なら
ポイント+1%
ポイント+1%
商品説明
【BOX】 ONE PIECEカードゲーム ブースターパック 受け継がれる意志 【OP-13】 ワンピースカードブランド:BANDAIご覧いただきありがとうございます。説明欄には必ず目を通していただき、ご購入よろしくお願い致します。【商品】■ ワンピースカード 受け継がれる意志 2BOX購入時、テープカットされておりました。中身は1BOX24パック入りを確認しまして、そのまんま戻しました。送料の関係によりパックを取り出しパックのみ発送します。箱がご入用の場合は購入前にコメントお願いします。注意事項落札後の返品返金は一切受け付けておりません。ご不明な点は事前に必ずご質問ください。種別パック ボックスワンピースカードコミパラ新時代の主役種別···ボックス合計枚数/個数···2| カテゴリー: | ゲーム・おもちゃ・グッズ>>>トレーディングカード>>>ワンピース カードゲーム |
|---|---|
| 商品の状態: | 未使用に近い","数回使用し、あまり使用感がない |
| 配送料の負担: | 送料込み(出品者負担) |
| 配送の方法: | 佐川急便/日本郵便 |
| 発送元の地域: | 未定 |
| 発送までの日数: | 1~2日で発送 |
レビュー
商品の評価:




 4.5点(3037件)
4.5点(3037件)
お店の情報
7,367
連絡・応対
4.3
配送スピード
4.3
梱包
4.3